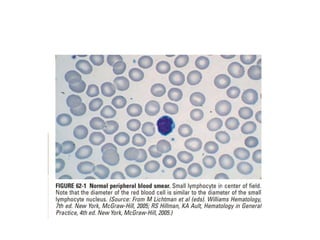
interpreting peripheral blood smears.pptx
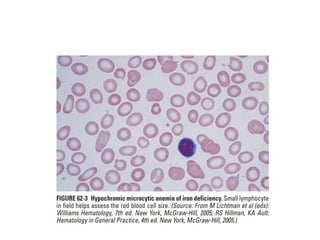
interpreting peripheral blood smears.pptx
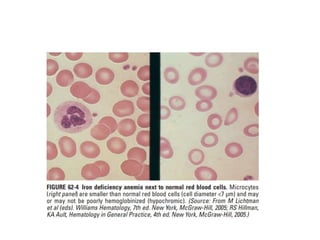
interpreting peripheral blood smears.pptx
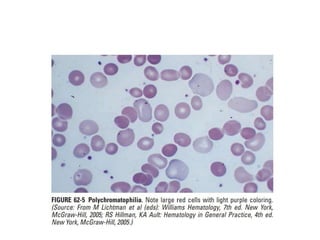
interpreting peripheral blood smears.pptx
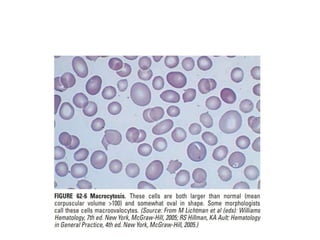
interpreting peripheral blood smears.pptx
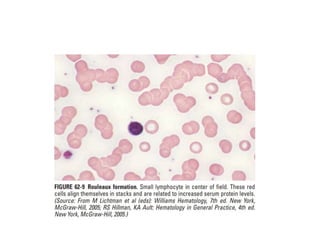
interpreting peripheral blood smears.pptx
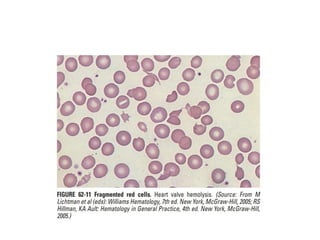
interpreting peripheral blood smears.pptx
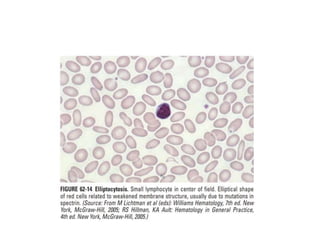
interpreting peripheral blood smears.pptx
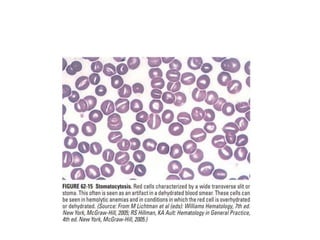
interpreting peripheral blood smears.pptx
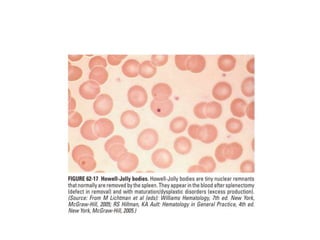
interpreting peripheral blood smears.pptx
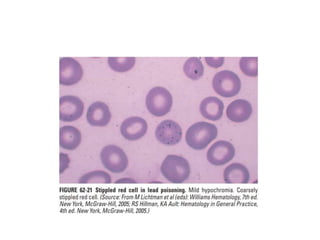
interpreting peripheral blood smears.pptx
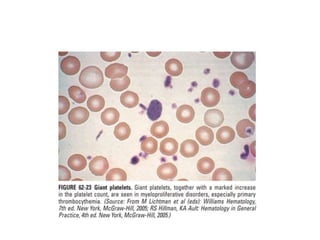
interpreting peripheral blood smears.pptx
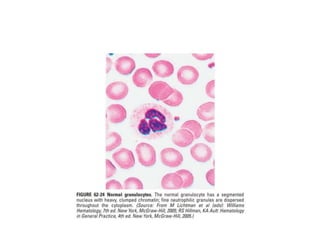
interpreting peripheral blood smears.pptx
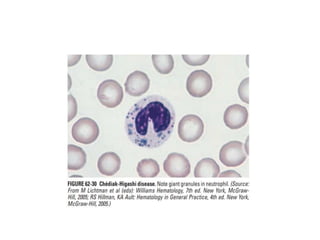
interpreting peripheral blood smears.pptx

This document provides guidance on interpreting peripheral blood smears by examining the morphology of platelets, red blood cells, white blood cells, and other cells. Key things to examine include size, shape, inclusions, and distribution of cells. Abnormal findings may indicate conditions such as infections, anemias, leukemias, and other disorders. Examining blood smears can provide clues to diagnose underlying medical problems.